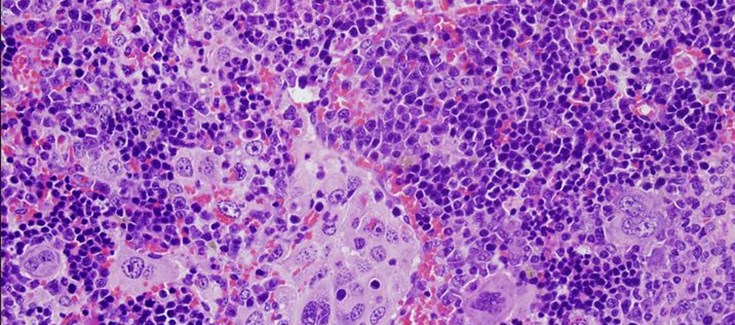

El grupo de investigación lideradopor el Dr. Xosé R. Bustelo, perteneciente al Centro de Investigación del Cáncer (CIC) de Salamanca y al Programa de Mecanismos de Progresión Tumoral del CIBER de cáncer (CIBERONC), acaba de publicar un artículo científico en donde se ha realizado un catálogo completo de las mutaciones del gen VAV1que se habían encontrado en distintos tipos de tumores humanos y, con frecuencia más alta, en un tumor originado en células de la sangre que se conoce como linfoma periférico de células T. Esto ha permitido identificar aquéllas que conllevan la activación descontrolada de este gen y que, por tanto, pueden contribuir al origen o progresión maligna de los cánceres en donde se han encontrado. En este estudio, cuyo primer firmante es el investigador del CIC y CIBER de cáncer Dr. Javier Robles-Valero, también demostró que el tipo de mutación más frecuente de VAV1 en tumores causa de forma autónoma la rápida aparición de linfomas periféricos de células T cuando se expresa en ratones. Este descubrimiento acaba de ser publicado en la revista científica EMBO Journal.
Este trabajo representó un tour de force de casi cinco años en los que colaboraron diferentes investigadores españoles pertenecientes al Centro de Investigación del Cáncer de Salamanca, la Universidad de Salamanca, el CSIC y el CIBERONC. La realización del trabajo fue posible gracias a financiación recibida desde la Fundación “La Caixa”, la Asociación Española contra el Cáncer , el Ministerio de Ciencia e Innovación, el Instituto de Salud Carlos III y la Junta de Castilla y León.
Los estudios recientes de la secuenciación del genoma de distintos tumores humanos han revelado que estos poseen miles de alteraciones genéticas (denominadas mutaciones) en una gran cantidad de genes. Tras estos estudios, el reto actual es saber qué mutaciones son realmente importantes para el desarrollo del cáncer y, al mismo tiempo, saber qué efectos causan y a través de qué caminos promueven la transformación de las células sanas en cancerosas. Dar respuesta a estas preguntas es esencial para poder diagnosticar de forma adecuada a los pacientes y, sobre todo, para encontrar dianas terapéuticas que permitan desarrollar fármacos específicos para los tumores que albergan dichas mutaciones. Sin tener esta información, no se podrá abordar la implantación de la medicina personalizada a nivel hospitalario de forma rutinaria.
Los estudios genómicos antedichos han hallado un gran número de mutaciones en el gen denominado VAV1 en varios tipos de tumores. Entre estos destacan, por la frecuencia en las que se han encontrado, los denominados linfomas periféricos de células T. Estos tumores se desarrollan a partir de los linfocitos T, unas células de nuestro sistema inmune que tienen por función el reconocimiento y destrucción de células de nuestro organismo que se han convertido en “peligrosas” bien por haberse transformado en células cancerosas o por haber sido infectadas por diversos tipos de virus como, por ejemplo, el que causa la Covid-19. Estas funciones positivas, sin embargo, se transforman en peligrosas cuando los propios linfocitos T sufren alteraciones genéticas que los hacen proliferar de forma descontrolada y promover la formación de linfomas. Este tipo de tumor se caracteriza por su agresividad, falta de opciones terapéuticas y una alta mortalidad que no ha mejorado significativamente en los últimos treinta años. Estos tumores constituyen, por tanto, unimportante reto a nivel clínico.
En el trabajo que se ha publicado en EMBO Journal, el grupo de investigación del Dr. Bustelo caracterizó la mayoría de las mutaciones detectadas hasta este momento en el gen VAV1 tanto en linfomas periféricos de células T y en otros tipos tumorales como, por ejemplo, el cáncer de pulmón no microcítico. De este estudio se han obtenido tres observaciones muy relevantes. Por un lado, se ha demostrado que la mayoría de estas mutaciones conllevan la activación descontrolada de este gen en las células tumorales y que, por tanto, son relevantes para el desarrollo de los tumores. También ha revelado que no todas las mutaciones del gen VAV1 son iguales desde un punto funcional. Al contario, estas podían clasificarse en varios subtipos dependiendo del grado de intensidad que provocaban en VAV1 o en el espectro de funciones que descontrolaban dentro de las células tumorales. Ello indica, por tanto, que cada uno de estos subtipos estará asociado a diferentes características patológicas y clínicas en los pacientes. Finalmente, el estudio ha demostrado también que el subtipo funcional más frecuente de las mutaciones de VAV1 en tumores humanos actúa como un “driver” (conductor) oncogénico plenamente autónomo, esto es, que es capaz de inducir tumores cuando se expresa en células T sanas sin necesidad de alteraciones genéticas en otros genes. Esta observación subraya más el hecho de que la presencia de estas mutaciones en los tumores no es trivial, sino que estas se encuentran en los mismos porque han sido las responsables principales de que dichos tumores se hayan originado. Según destaca el primer firmante de este trabajo, el Dr. Robles-Valero, “Hasta ahora se desconocía la relevancia de las mutaciones del gen VAV1 en el plano funcional y clínico. Gracias a este trabajo, ahora sabemos qué mutaciones son importantes, qué es lo que hacen y cómo influyen en la adquisición de las propiedades malignas de las células tumorales. Saber estos efectos también nos permitirá en el futuro próximo diseñar nuevos fármacos antitumorales”.
En el trabajo se ha desarrollado también un modelo animal que permite generar linfomas en ratones tras la expresión de mutantes de VAV1 en linfocitos T sanos. Usando técnicas genómicas y bioinformáticas, se ha podido comprobar que estos linfomas reproducen la gran mayoría de las características clínicas, patológicas y moleculares de los linfomas periféricos de células T de pacientes. También ha permitido descubrir talones de Aquiles de estos linfomas que, a partir de ahora, servirán para buscar vías para atacar y destruir este tipo de linfomas. Estos modelos animales supondrán también una vía excepcional, a partir de ahora, para probar a nivel pre-clínico fármacos que se desarrollen contra dichos linfomas
Como resalta el Dr. Bustelo, “Junto con la demostración de que estas mutaciones de VAV1 actúan como agentes causales del cáncer, el modelo animal desarrollado en este estudio nos ha permitido desarrollar linfomas de células T que son muy similares a las que se encuentran en pacientes. Esto nos permitirá identificar con más facilidad los puntos débiles que poseen estos linfomas, identificar fármacos contra los mismos y, finalmente, probar la efectividad de dichos fármacos de forma pre-clínica en este modelo animal. Esto es especialmente relevante en este tipo de tumores, dada la dificultad que ha existido hasta ahora para clasificarlos, estudiarlos y tratarlos de forma eficaz”.
Referencia del artículo
Título: Cancer-associated mutations in VAV1 trigger variegated signaling outputs and T-cell lymphomagenesis
Autores: Javier Robles-Valero; Lucía Fernández-Nevado; Luis Francisco Lorenzo-Martín; Myriam Cuadrado; Isabel Fernández-Pisonero; Sonia Rodríguez-Fdez; Elsa Natividad Astorga-Simón; Antonio Abad; Rubén Caloto y Xosé R Bustelo
Acceso a publicación:
https://www.embopress.org/doi/full/10.15252/embj.2021108125